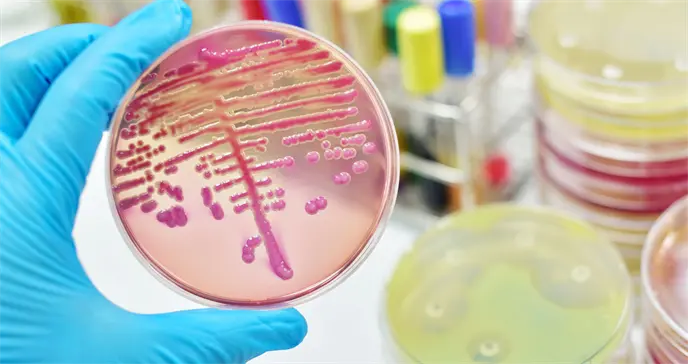
As&iacute; es la Klebsiella, una superbacteria que resiste a los antibi&oacute;ticos y se contagia en los hospitales

La transmisión de bacterias en los hospitales es una realidad muy común. Actualmente, entre un 6 y un 8% de los pacientes ingresados en un centro sanitario se contagia de una bacteria externa a su enfermedad.
La Klebsiella es una bacteria que se encuentra en la flora intestinal de la mayoría de la población sin causar ningún daño. Esta bacteria nos ayuda a protegernos de otros gérmenes y a hacer la digestión.
Es un microorganismo que puede producir infecciones de pulmón, de intestino, en las vías urinarias o en heridas. Su variedad más conocida y de mayor relevancia clínica es la Klebsiella pneumoniae y en su mayoría se contagia en hospitales, llegando a causar enfermedades graves o incluso la muerte.
Este tipo de infección nosocomial adquiere fuerza como consecuencia del frecuente uso de antibióticos en las instalaciones sanitarias, ya que favorece a su resistencia y es conocida como una "superbacteria".
¿Cuándo es peligrosa?
Esa bacteria resulta peligrosa fuera del intestino. Si llega a otras partes del organismo humano, puede causar infecciones. Normalmente, provocan neumonía, sepsis, infecciones en heridas y en el tracto urinario. Si no se pueden controlar, esas infecciones pueden causar la muerte del enfermo.
¿Cuál es la dificultad de su tratamiento?
Uno de los principales problemas que genera esta bacteria es la dificultad de su tratamiento, ya que es resistente a la mayor parte de los antibióticos.
¿Cómo se contagia?
Esta bacteria suele transmitirse por contacto con la piel, mucosas, heces, heridas u orina de una persona infectada. También suele transmitirse a través del contacto con materiales que han quedado contaminados como catéteres, sondas o ventilación asistida o la superficie de quirófanos.

¿A que pacientes afecta?
Mucha gente es portadora, es decir llevan la bacteria sin que les produzca infección, a partir de ahí, siempre tienen más riesgo de desarrollar la infección o de contagiarse los pacientes inmunosuprimidos donde la bacteria puede progresar y generar infección.
Son especialmente susceptibles a ella los pacientes ingresados en unidades de cuidados intensivos, neonatos, pacientes con enfermedad pulmonar obstructiva crónica, diabéticos o alcohólicos. Se trata de pacientes con alteraciones de las defensas orgánicas.
¿Qué enfermedades causa?
Su actividad, que puede generar neumonía, sepsis u otros tipos de infecciones, se ha cobrado vidas humanas tanto a nivel nacional como internacional. En España, le costó la vida a una joveningresada en el Hospital Reina Sofía y este lunes, a dos bebés en el Vall d´Hebron de Cataluña.
En el exterior, una mujer falleció en Estados Unidos. Tras habérsele realizado una serie de pruebas, se decretó que la superbacteria era resistente a 26 tipos de antibióticos.
Cómo se detecta y se trata la infección
Para comprobar si un paciente ha desarrollado la infección se deben obtener muestras de las mucosas de la cavidad bucal y nasal, del tracto respiratorio superior (faringe y laringe), orina, sangre u otros tejidos infectados, y someter la muestra a una tinción de Gram para identificar la bacteria, que muestra un tono rosado suave.
Respecto al tratamiento, se basa en la administración de antibióticos por vía intravenosa, y si la infección se ha contraído fuera del ámbito hospitalario puede curarse con cefalosporinas o fluoroquinolonas, aunque en el caso de que se haya adquirido en el hospital la bacteria suele ser resistente a estos medicamentos.